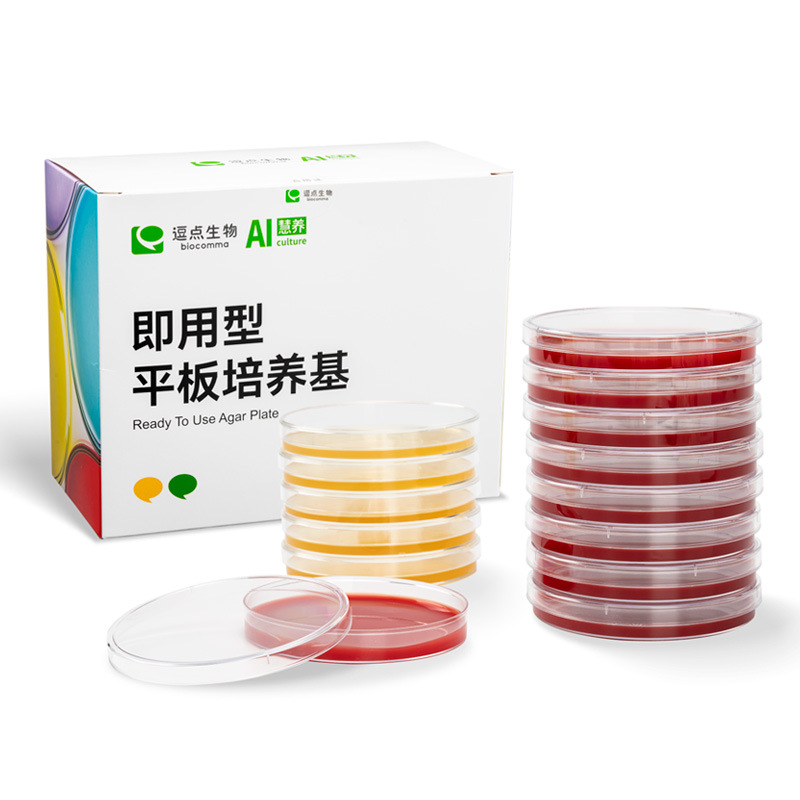
逗点生物Aiculture沙门氏菌显色培养基平板 微生物培养基

1688工业品为您提供在线免费查询更多履带挖掘机详细参数、实时报价、规格一览表。更多关于履带挖掘机多少钱一台/履带挖掘机报价明细/履带挖掘机规格型号表/履带挖掘机价格一览表/履带挖掘机官方报价等咨询,尽在1688工业品。询底价>
为你找到生命科学相关产品

ANTR1 rabbit pAb
¥900
售10+瓶
上海
在线询价

Bestbio贝博 一氧化氮检测试剂盒 BB-4701 (现货)
¥800
售10+瓶
上海
在线询价
逗点生物Aiculture沙门氏菌显色培养基平板 微生物培养基
¥330
售10+袋
广东深圳
在线询价

Bestbio贝博 磷酸酶抑制剂混合物片剂 BB-3373
¥80
售10+瓶
上海
在线询价

ADM rabbit pAb
¥900
售10+瓶
上海
在线询价

Bestbio贝博 细胞质染色试剂 CDCFDA BB-441939-500ul (现货)
¥800
售10+瓶
上海
在线询价

方形培养基瓶(血清瓶) 125mL方形瓶,非无菌
售10+箱
广东深圳
在线询价

AL2CL rabbit pAb
¥900
售10+瓶
上海
在线询价

AKAP 14 rabbit pAb
¥900
售10+瓶
上海
在线询价

Bestbio贝博 血小板稀释液(计数液) BB-45014
¥120
售10+瓶
上海
在线询价

Bestbio贝博 Tris-Tricine阳极缓冲液(5×,pH8.9) BB-37192
¥220
售10+瓶
上海
在线询价

CFSE / 7-AAD双染细胞毒性检测试剂盒 BB-42142-500T (现货)
¥900
售10+瓶
上海
在线询价
相关商品推荐
Bestbio贝博 乳酸脱氢酶染色试剂盒(H4型,LDH1) BB-44317-2×50Arrdc4 rabbit pAbBestbio贝博 Tris-Tricine阳极缓冲液(5×,pH8.9) BB-37192Bestbio贝博 黏着斑蛋白(vinculin)荧光染色试剂盒 BB-44169
Bestbio贝博 ATP酶检测试剂盒 BB-47195Bestbio贝博 液体样本线粒体提取试剂盒 BB-36016 现货AP-2γ rabbit pAb103591-100实时ATP生成速率测定试剂盒Agilent安捷伦生物分析试剂





